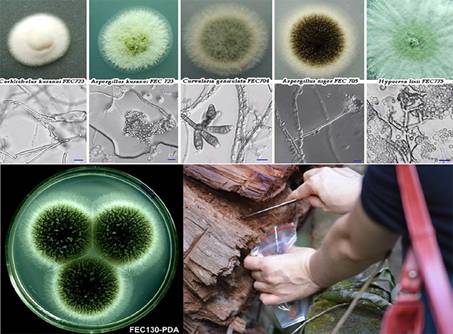

1. Nghiên cứu cơ bản
– Nghiên cứu cơ sở khoa học và thực tiễn phục vụ xây dựng chiến lược, quy hoạch phát triển ngành Công nghiệp sinh học và chế biến thực phẩm với cơ cấu hợp lý, đảm bảo phát triển biền vững.
– Nghiên cứu điều tra, đánh giá đa dạng sinh học phục vụ cho việc phát triển Sưu tập giống vi sinh vật công nghiệp.
– Nghiên cứu đánh giá khả năng ứng dụng các chủng vi sinh vật được phân lập phục vụ cho việc phát triển ngành Công nghiệp sinh học và Công nghiệp chế biến thực phẩm.
– Nghiên cứu xây dựng catalog vi sinh vật công nghiệp phục vụ cho việc khai thác nguồn gen.
2. Nghiên cứu ứng dụng và triển khai công nghệ – Ứng dụng các kết quả nghiên cứu khoa học và công nghệ vào sản xuất, kinh doanh.
– Tổ chức sản xuất tại Viện một số công nghệ không cần đòi hỏi nhà xưởng rộng, vốn lớn nhưng lại cần cơ sở vật chất tốt với trang thiết bị hiện đại
– Chuyển giao công nghệ cho các doanh nghiệp thông qua các hợp đồng kinh tế.
– Hợp tác sản xuất kinh doanh với các tổ chức và cá nhân có nhu cầu.
– Dịch vụ khoa học công nghệ với các doanh nghiệp và các cơ quan quản lý nhà nước bao gồm: dịch vụ phân tích và giám định nguyên liệu và sản phẩm thực phẩm, tư vấn đầu tư…
– Nghiên cứu thu nhận các hợp chất có hoạt tính sinh học từ vi sinh vật phục vụ cho công nghiệp y-dược và công nghiệp thực phẩm.
– Nghiên cứu khai thác các hợp chất có hoạt tính sinh học từ thực vật phục vụ cho việc sản xuất các thực phẩm chức năng và công nghiệp y – dược.
– Nghiên cứu sử dụng các chủng vi sinh vật, chế phẩm vi sinh vật phục vụ sản xuất thực phẩm và công nghệ chế biến.
– Nghiên cứu tạo các chế phẩm vi sinh vật cho sản xuất thức ăn chăn nuôi.
– Nghiên cứu sản xuất các chế phẩm vi sinh bảo vệ môi trường.
– Nghiên cứu sử dụng các vi sinh vật kiểm định phục vụ cho việc phát triển các sản phẩm y – dược và thực phẩm.
– Nghiên cứu sản xuất các sản phẩm thực phẩm chức năng.
– Nghiên cứu các biện pháp đảm bảo an toàn thực phẩm phổ biến cho các doanh nghiệp chế biến thực phẩm.
– Nghiên cứu xây dựng các quy chuẩn, tiêu chuẩn quốc gia về nguyên liệu và sản phẩm thực phẩm.

- Đề tài, dự án do Viện Công nghiệp thực phẩm chủ trì giai đoạn 2015-2025
Các đề tài, dự án thực hiện tại Viện Công nghiệp thực phẩm trong giai đoạn 2010-2015 được trình bày ở Bảng sau đây a. Các nhiệm vụ cấp Nhà nước, đề tài, dự án thuộc chương trình KHCN- Nghiên cứu quy trình công nghệ điều chế Lovastatin làm thuốc (CT Hóa dược) (2011-2012).
- Nghiên cứu công nghệ sản xuất etanol từ rỉ đường bằng phương pháp cố định tế bào trong hệ thống lên men liên tục (CT NLSH) (2010-2012).
- Nghiên cứu quy trình công nghệ sản xuất các axit béo không thay thế và Vitamin E từ nguồn phụ phẩm chế biến dầu thực vật (CT Hóa dược) (2011-2012).
- Nghiên cứu phát triển cây cải dầu cho đồng bào các dân tộc vùng núi đá tỉnh Hà Giang (2011-2013).
- DA: Hoàn thiện công nghệ và hệ thống thiết bị sản xuất rượu gạo truyền thống sản lượng 800 000l/năm (CT KC07) (2012- 2015).
- Nghiên cứu sản xuất chủng khởi động và ứng dụng trong sản xuất sữa chua, phomat (CT KC07) (2012-2015).
Đề tài, dự án độc lập
-
Sản xuất thử nghiệm rượu vang chất lượng cao tại Việt Nam (2012-2015).Hợp tác nghị định thư
-
Nghiên cứu thu nhận chế phẩm enzym Tanaza từ chủng nấm mốc Aspergillus theo phương pháp lên men rắn và ứng dụng trong công nghiệp chế biến thực phẩm (2011-2013).
-
Hợp tác Nghiên cứu công nghệ sản xuất thực phẩm chức năng từ vi khuẩn Probibiotic (2011-2013).
-
Nghiên cứu công nghệ sản xuất chất thơm từ các chủng nấm men chuyển hóa chất béo (Oleaginous yeast) ứng dụng trong công nghiệp sản xuất thực phẩm (2011-2013).
Chương trình CNSH trong chế biến
- Nghiên cứu sản xuất một số loại rượu truyền thống từ gạo đặc sản của Đồng bằng sông Cửu Long (2010-2012).
- Nghiên cứu sản xuất một số sản phẩm thực phẩm chức năng từ đậu tương (2010-2012).
- Nghiên cứu công nghệ sản xuất phytase tái tổ hợp từ nấm men (2010-2012).
- Sản xuất chế phẩm nấm mốc và ứng dụng trong chế biến chao ở quy mô vừa và nhỏ (2011-2012).
- Sản xuất một số loại rượu đặc sản từ thốt nốt (2011-2012).
- Nghiên cứu ứng dụng enzym trong chế biến hạt tiêu trắng để nâng cao chất lượng và hạ giá thành sản phẩm (2011-2012).
- Nghiên cứu sản xuất isomalto-oligosaccharid bằng enzyme và ứng dụng trong chế biến thực phẩm, dược phẩm (2011-2012).
- Nghiên cứu ứng dụng enzyme trong bảo quản sữa tươi và một số sản phẩm từ sữa (2011-2012).
- Nghiên cứu công nghệ và thiết bị sản xuất rượu Whisky từ nguyên liệu thay thế của Việt Nam (2013-2014).
- Nghiên cứu công nghệ sản xuất váng sữa lên men giàu protein (2013-2014).
- Nghiên cứu công nghệ sản xuất Lycopene từ cà chua và ứng dụng trong công nghiệp chế biến thực phẩm (2014-2015).
- Nghiên cứu công nghệ sản xuất đường chức năng Erythritol từ tinh bột (2014-2015).
- Nghiên cứu công nghệ sản xuất xylanase tái tổ hợp và ứng dụng để sản xuất thức ăn chăn nuôi (2014-2015).
- DA Hoàn thiện công nghệ sản xuất maltooligosacharit giàu maltotriose sử dụng trong công nghiệp thực phẩm (2013-2014).
Nhiệm vụ thường xuyên
Nhiệm vụ Quỹ gen
- Bảo tồn và lưu giữ nguồn gen vi sinh vật công nghiệp thực phẩm (nhiệm vụ hàng năm).
- Khai thác và phát triển nguồn gen vi sinh vật thực phẩm phục vụ yêu cầu sản xuất một số loại rượu đặc sản của Việt Nam (2013-2014).
- Khai thác và phát triển nguồn gen vi sinh vật tạo hương để sản xuất một số loại nước mắm đặc sản (2014-2015).
B. Các nhiệm vụ cấp Bộ
- Nghiên cứu xây dựng phương pháp kiểm định các loại rượu cao cấp (whisky, cognac) để phát hiện hàng giả, hàng kém chất lượng trên thị trường Việt nam (2010).
- Nghiên cứu công nghệ sản xuất chế phẩm dịch chiết lá tía tô giàu axít rosmarinic để ứng dụng trong sản xuất đồ uống chức năng (2010).
- Nghiên cứu công nghệ sản xuất một số sản phẩm trà sữa uống liền từ nguyên liệu chè Việt Nam (2010).
- Nghiên cứu cải tiến công nghệ và thiết bị sản xuất rượu đế Bến Gỗ (Đồng Nai) (2010-2011).
- Nghiên cứu công nghệ sản xuất chế phẩm anthocyanin để ứng dụng trong sản xuất thực phẩm chức năng (2010-2011).
- Nghiên cứu công nghệ khai thác tinh dầu và các chất có hoạt tính sinh học từ quả và lá cây mác mật Clausena excavata (2010-2011).
- Nghiên cứu công nghệ sản xuất tinh bột acetat sử dụng trong chế biến thực phẩm (2010)
- Nghiên cứu công nghệ sản xuất đồ uống chức năng từ quả táo mèo bằng phương pháp lên men axetic sử dụng vi khuẩn Acetobacter (2010-2011).
- Nghiên cứu công nghệ sản xuất sữa ngô đặc giàu đạm (2010).
- Nghiên cứu sản xuất chế phẩm giàu sphingolipit từ sữa làm nguyên liệu cho sản xuất thực phẩm chức năng (2011).
- Nghiên cứu phương pháp xác định Methyl-thủy ngân trong cá và một số sản phẩm thực phẩm từ cá bằng phương pháp sắc ký khí gắn với Detector cộng kết điện tử (GC/ECD) (2011).
- Nghiên cứu quy trình công nghệ sản xuất nước uống giàu glycozit từ quả la hán (2011).
- Nghiên cứu công nghệ sản xuất chế phẩm giàu flavonoid từ lá sen để ứng dụng trong đồ uống (2012).
- Nghiên cứu xác định acrylamide trong một số sản phẩm thực phẩm bằng phương pháp sắc ký khí khối phổ (GC/MS) (2012).
- Hoàn thiện qui trình công nghệ sản xuất bột trà hòa tan từ nguyên liệu trà Bảo Lộc (2012).
- Nghiên cứu công nghệ thu nhận Phytosterol từ phụ phẩm chế biến dầu thực vật Việt Nam (2012-2013).
- Nghiên cứu công nghệ sản xuất một số thực phẩm chức năng từ sữa ong chúa (2012-2013).
- Sản xuất thử nghiệm một số sản phẩm đồ uống thảo mộc từ lá tía tô và hibicus (2012).
- Sản xuất thử nghiệm một số sản phẩm đồ uống thảo mộc từ lá tía tô và hibicus (2013).
- Nghiên cứu phát triển phương pháp xác định chất tạo ngọt nhân tạo (sacarin) và một số chất bảo quản (methyl-, ethyl-, isobutyl- và butyl-p-hydroxybenzoate) trong nước chấm, gia vị và một số sản phẩm đồ uống bằng sắc ký lỏng hiệu năng cao (HPLC) (2013).
- Nghiên cứu tách chiết một số hoạt chất tự nhiên từ quả cà phê xanh ứng dụng trong sản xuất thực phẩm và dược phẩm (2013-2014).
- Hoàn thiện công nghệ sản xuất dầu hạt bí đỏ bằng phương pháp enzyme (2013-2014).
- Nghiên cứu công nghệ sản xuất chế phẩm giàu flavonoid từ hoa kim ngân và ứng dụng trong sản xuất đồ uống (2013).
- Nghiên cứu công nghệ trích ly và tinh chế gamma-oryzanol từ dầu cám gạo (2013).
- Nghiên cứu công nghệ sản xuất bột protein từ đậu tương ứng dụng trong thực phẩm ăn kiêng (2014).
- Nghiên cứu công nghệ sản xuất chế phẩm giàu isothiocyanate từ rau cải xoong ứng dụng trong sản xuất thực phẩm chức năng (2014).
- Nghiên cứu ứng dụng enzyme để sản xuất lecithin giàu phosphatidylcholine ứng dụng trong sản xuất thực phẩm chức năng (2014).
- Hoàn thiện qui trình công nghệ sản xuất tỏi đen và tạo ra một số sản phẩm có thành phần tỏi đen (bột tỏi đen, paste tỏi đen, chocolate tỏi đen) (2014-2015).
- Nghiên cứu tách chiết một số hoạt chất tự nhiên từ quả cà phê xanh ứng dụng trong sản xuất thực phẩm và dược phẩm (2014).
- Hoàn thiện qui trình công nghệ sản xuất tỏi đen và tạo ra một số sản phẩm có thành phần tỏi đen (bột tỏi đen, paste tỏi đen, chocolate tỏi đen) (2014-2015).
- Nghiên cứu tạo chế phẩm synbiotic từ chất xơ hòa tan có trong lá và củ khoai lang (2015-2016).
- Nghiên cứu quy trình công nghệ chế biến một số thực phẩm từ thịt quả cacao (2015).
- Nghiên cứu công nghệ sản xuất bột giàu xyloglucan từ hạt me (Tamarindusindica L.) vàứng dụng làm phụ gia trong sản xuất thực phẩm (2015).
- Nghiên cứu công nghệ sản xuất một số loại đồ uống từ quả me rừng (mác kham) (2015).
- Nghiên cứu công nghệ thu nhận tinh dầu và các chất có hoạt tính sinh học từ cây ngải cứu Artemisia vulgaris L (2015-2016).
- DA: Hoàn thiện công nghệ sản xuất thử nghiệm một số sản phẩm đồ uống thảo mộc từ lá Sen (2015).
- DA: sản xuất thử nghiệm một số thực phẩm chức năng từ sữa ong chúa (2015-2016).
C. Các đề tài cấp Tỉnh
- Hoàn thiện công nghệ sản xuất bột ngũ cốc dinh dưỡng chất lượng cao cho người cao tuổi (Hà Nội) (2010-2011).
- Nghiên cứu công nghệ sản xuất đường chức năng Isomaltulose từ Saccharoza (Hà Nội) (2010-1011).
- Nghiên cứu thu nhận chất chiết cám gạo lên men và ứng dụng (Hà Nội) (2010-2011).
- Nghiên cứu công nghệ bảo quản và chế biến một số sản phẩm từ hạt dẻ tươi (Cao Bằng) (2010-2012).
- Nghiên cứu xây dựng quy trình công nghệ sản xuất Canxi lactat từ nguyên liệu tinh bột sắn (Hà Nội) (2011-2012).
- Nghiên cứu công nghệ chế biến một số sản phẩm thực phẩm từ Hà thủ ô đỏ Cao Bằng (Cao Bằng) (2012-2013).
- Nghiên cứu công nghệ sản xuất đường chức năng Steviol glycosid, stevioside và rebaudioside A từ cỏ ngọt và ứng dụng trong công nghiệp (Hà Nội) (2012-2013).
- Nghiên cứu thiết kế và chế tạo thiết bị sấy chân không nhiệt độ thấp dạng bơm nhiệt có ngưng lạnh đẻ sấy các sản phẩm sinh học đạt chất lượng cao (2013-2014).
- Nghiên cứu công nghệ sản xuất Mannitol bằng phương pháp lên men và ứng dụng trong công nghiệp thực phẩm (2014-2015).
D. CÁC ĐỀ TÀI, DỰ ÁN KHÁC
- Khả năng công nghệ đặc hữu của một số loài Moniliella mới (Quỹ phát triển KH&CN Quốc gia) (2011-2012).
- Đa dạng di truyền phân tử của nấm men Moniliella tại Việt Nam(Quỹ phát triển KH&CN Quốc gia) (2014-2015).
- Nhánh đề tài: Nghiên cứu ứng dụng công nghệ enzyme để sản xuất protein thủy phân từ cá tạp và phế liệu trong nhà máy chế biến cá (2010).
- Nhánh đề tài: Nghiên cứu sản xuất một số thực phẩm chức năng cho người bệnh tiểu đường từ lá dâu tằm (2010).
- Nhánh đề tài: Xây dựng qui trình công nghệ sản xuất Eragen qui mô 20 kg/mẻ (2010).
- Nhánh đề tài: Xây dựng qui trình công nghệ sản xuất Lycatab C qui mô 20 kg/mẻ (2010).
- Nhánh dự án: Hoàn thiện ứng dụng công nghệ vi sinh và enzim trong sản xuất nước mắm (2011).
- Nhánh đề tài: Nghiên cứu ứng dụng Endo-xylanase để sản xuất Arabinnoxylan từ cám gạo làm thực phẩm chức năng (2011-2012).
- Nhánh đề tài: Nghiên cứu xác định quy trình công nghệ chế biến nước ổi probiotic (2011).
- Nhánh đề tài: Tuyển chọn các chủng VSV phù hợp để sản xuất nước giải khát lên men từ chè (2011-2012).
- Nhánh đề tài: Nghiên cứu công nghệ sản xuất thực phẩm chức năng từ đậu tương lên men dùng cho người bệnh tiểu đường (2011-2012).
- Nhánh dự án: sản xuất dấm ăn bằng công nghệ vi sinh (2015).
- Nhánh đề tài: Nghiên cứu sản xuất polymaltose từ tinh bột và tạo các phức hợp sắt-polymaltose (IPC) và canxi hydroxyaapatite-polymaltose (HAP ứng dụng trong dược phẩm (2014-2015).
- Nhánh đề tài: Nghiên cứu công nghệ vi nang tinh dầu tỏi, gừng (2014-2015).
- Nhánh đề tài: Nghiên cứu công nghệ thuộc da trâu, bò thân thiện với môi trường phục vụ sản xuất các mặt hàng da thuộc có giá trị cao, thay thế nhập khẩu (2014-2015).
- Nhánh dự án: Ứng dụng công nghệ enzyme trong chế biến một số sản phẩm từ quả dâu tằm và chanh leo (2014-2015).
